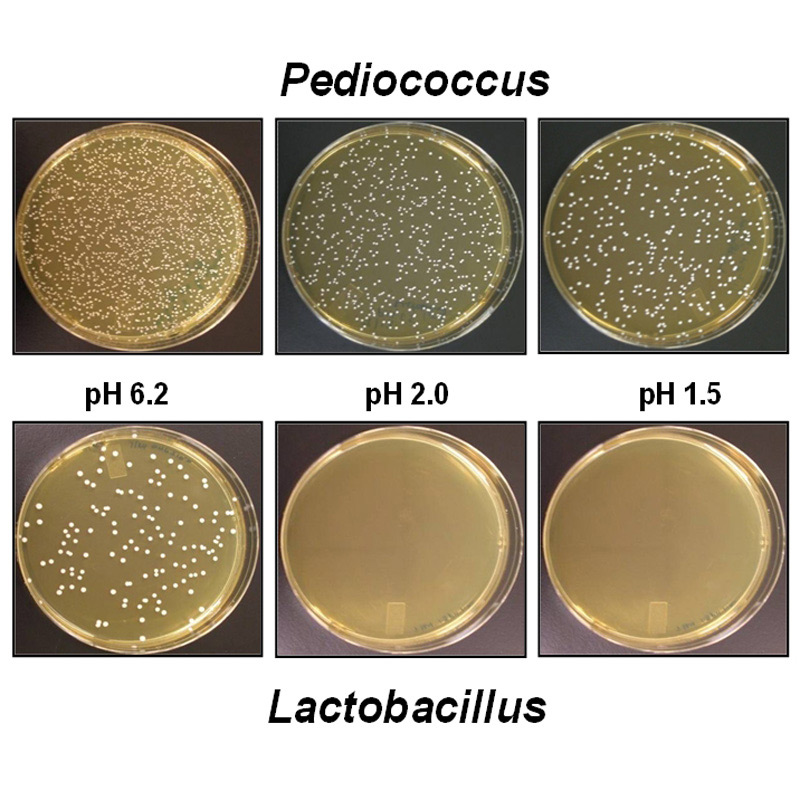
maxxidigest+ canine probiotics proven to work

maxxidigest+ is a 2-for-1 therapeutic formula that contains variety of ingredients that have been carefully selected for their roles in supporting the digestive and immune system in our dogs.
maxxidigest+ supports and maintains optimal digestive health by enhancing the intestinal tract, promoting healthy mucosal lining and stabilizing and maintaining the right pH balance in the gut
Can help with leaky gut, intestinal repair, irritable bowel syndrome (IBS), inflammatory bowel disease (IBD), yeast infection, atopic dermatitis, food allergy, flatulence, post-surgical infections, and chronic diarrhea (including antibiotic associated stomach upset)
It is not about quantity, it is about quality. Pediococcus acidilactici probiotics are scientifically proven to survive the acidic stomach environment in our dogs and make it to the GI tracts for maximum health benefits.
At the time of manufacturing we add 50% overage which guarantees 1 billion cfu per serving at the date of expiry, not only at the date of manufacturing
Natural flavour. Suitable for all dog breeds. Made in the USA in GMP and NASC (National Animal Supplement Council) certified manufacturing facility using NON-GMO pharmaceutical Human Grade ingredients, tested for purity and potency.
Benefits
- Not just probiotic, 2-for-1 therapeutic formula to get your dog's digestions imbalance and immune system under control
- Contains the best probiotics for dogs, as guaranteed to survive in the stomach's acidic environment
- Restores digestive health, promotes healthy mucosal lining, enhances digestion, supports healthy gastrointestinal tract, offers diarrhea relief, supports normal gut permeability, works as probiotic and prebiotic, helps with food sensitivities, combats yeast infection and allergies, improves the hormone function and supports the immune system
- Can be given with antibiotics
- Easy to administer powder for fast absorption, allowing more accurate dosing for dog of any size, it is easy to increase or decrease the dosage as needed and it’s long lasting